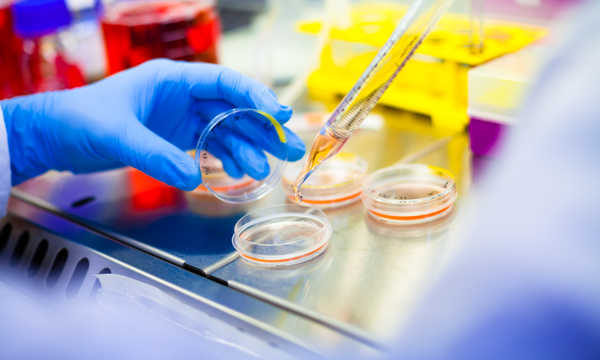
Leczenie ran i oparzeń z zastosowaniem komórek macierzystych polega na wykorzystaniu ich zdolności do regeneracji tkanek i przyspieszania procesu gojenia

O komórkach macierzystych słyszy się coraz więcej, choćby w aspekcie pobierania i przechowywania bogatej w nie krwi pępowinowej. Przyczyną zainteresowania tymi strukturami jest to, że mają one duże zdolności rozmnażania i różnicowania się – nazwa „macierzyste” wzięła się stąd, że mogą się przekształcać w różne typy komórek organizmu.
Jednym z zastosowań komórek macierzystych, budzącym spore zainteresowanie wśród lekarzy, jest leczenie ran i oparzeń. Szczególnie dotyczy to tych postaci zmian, które trudno opanować innymi dostępnymi metodami – a takowe nie są wcale rzadkie.
Jak informują autorzy pracy „Concise Review: Role of Mesenchymal Stem Cells in Wound Repair”, w samych Stanach Zjednoczonych rocznie odnotowuje się od 5 do 7 milionów przypadków przewlekłych, niegojących się ran.
Komórki macierzyste a gojenie ran

W prawidłowej skórze występują komórki macierzyste. W przypadku zranienia czy drobnego oparzenia aktywują się i biorą udział (wraz z otaczającą je macierzą oraz czynnikami wzrostu) w procesach regeneracyjnych.
Przy większych oparzeniach i przewlekłych ranach liczba i funkcja tych komórek mogą być zaburzone. Dlatego powstała koncepcja, aby wspomóc gojenie skóry poprzez dostarczanie brakujących komórek macierzystych w dane miejsca.
Jak to działa w praktyce? Po urazie skóra przechodzi kolejne etapy gojenia (hemostaza, zapalenie, proliferacja, przebudowa). Komórki macierzyste – szczególnie mezenchymalne – wspierają każdy z tych etapów głównie dzięki działaniu pośredniemu (parakrynnemu), czyli poprzez wydzielanie białek, cytokin i pęcherzyków zewnątrzkomórkowych, które „regulują” zachowanie innych komórek skóry.
Mechanizmy działania komórek macierzystych
- Immunomodulacja i wygaszanie nadmiernego stanu zapalnego – obniżanie poziomu prozapalnych cytokin i wspieranie przejścia makrofagów z fenotypu prozapalnego do naprawczego, co ogranicza przewlekłość rany.
- Pobudzanie angiogenezy – zwiększanie wytwarzania czynników sprzyjających powstawaniu naczyń (np. VEGF), co poprawia ukrwienie i zaopatrzenie tkanek w tlen.
- Stymulacja keratynocytów i fibroblastów – przyspieszanie namnażania i migracji komórek naskórka oraz regulacja aktywności fibroblastów, co sprzyja zamknięciu rany i prawidłowemu odkładaniu macierzy zewnątrzkomórkowej.
- Kontrola przebudowy tkanki – wpływ na równowagę między metaloproteinazami a ich inhibitorami, co pomaga ograniczać nadmierne bliznowacenie.
- Ograniczanie stresu oksydacyjnego i działania drobnoustrojów – wydzielanie czynników o właściwościach antyoksydacyjnych i peptydów przeciwdrobnoustrojowych, co może wspierać ochronę rany przed zakażeniem.
Istotne jest to, że tylko niewielka część podanych komórek na stałe wbudowuje się w gojącą się tkankę. Główny efekt terapeutyczny wynika z „sekretomu” komórek (uwalnianych czynników i pęcherzyków, takich jak egzosomy), które kierują procesem naprawy i rekrutują własne komórki organizmu do działania.
Zastosowania w dermatologii i medycynie estetycznej
W dziedzinie medycyny estetycznej i dermatologii wykorzystanie komórek macierzystych otwiera nowe możliwości w odnowie skóry. Dzięki ich zdolności do samoregeneracji oraz wydzielania czynników wzrostu terapie oparte na komórkach macierzystych przyczyniają się do uzyskania zdrowszej, bardziej elastycznej i młodziej wyglądającej skóry.
To nie tylko tajemnica piękna, ale także zdrowia skóry, która odgrywa kluczową rolę w naszym codziennym życiu.
Źródła komórek macierzystych

Komórki macierzyste pochodzą albo od samego pacjenta, albo z tzw. banków tkanek. Uzyskać je można z różnych miejsc, takich jak skóra, tkanka tłuszczowa czy szpik kostny. Za najbogatsze ze źródeł uznaje się tkankę tłuszczową. Jak mówi chirurg dr hab. Marek Kawecki w rozmowie opublikowanej na portalu rynekzdrowia.pl, ze 100 ml tej tkanki uzyskać można nawet 400 000 komórek macierzystych.
Ta obfitość komórek macierzystych w tkance tłuszczowej sprawia, że jest ona szczególnie atrakcyjnym źródłem do wykorzystania w procedurach medycyny regeneracyjnej. Wysoka dostępność komórek macierzystych z tkanki tłuszczowej znacząco przyczynia się do skuteczności terapii oraz wspiera procesy regeneracyjne w organizmie pacjenta.
Ostatnie badania wskazują również na rodzaj komórek macierzystych pozyskanych z błony płodowej, które posiadają dużą zdolność do różnicowania się i są mniej kontrowersyjne niż inne źródła, takie jak komórki embrionalne. Pracując nad optymalizacją metod izolacji i hodowli, naukowcy dążą do zwiększenia skuteczności terapii komórkowych oraz minimalizacji ryzyka związanego z potencjalnym odrzutem czy reakcją alergiczną.
Rodzaje komórek macierzystych a leczenie ran
W kontekście ran i oparzeń najczęściej mówi się o mezenchymalnych komórkach macierzystych (MSC), które mają silne właściwości immunomodulujące i proangiogenne. W zależności od źródła mogą różnić się profilem wydzielanych czynników oraz potencjałem do namnażania. Komórki z tkanki tłuszczowej często charakteryzują się wysoką dostępnością i aktywnością proangiogenną, ze szpiku kostnego – dłuższą historią badań, a z tkanek okołopłodowych – dużym potencjałem proliferacyjnym.
Istnieją też skórne komórki macierzyste (np. z naskórka i mieszków włosowych), które bezpośrednio odbudowują naskórek, ale są trudniejsze do izolacji i wymagają wyspecjalizowanych procedur.
Komórki embrionalne i indukowane pluripotencjalne (iPSC) pozostają rozwiązaniami badawczymi ze względu na kwestie etyczne i bezpieczeństwa (m.in. ryzyko nieprawidłowego różnicowania), dlatego w leczeniu ran nie stanowią rutynowej opcji. Na skuteczność terapii wpływają także czynniki dawcy (wiek, choroby współistniejące) i sposób przygotowania preparatu.
Terapie komórkowe w ranach i oparzeniach

Samo pobranie to jednak dopiero początek. Do leczenia ran i oparzeń wykorzystuje się komórki macierzyste w różnych postaciach.
Komórki macierzyste są dostępne m.in. w formie:
- nakładanych plastrów,,
- w postaci płynnej,
- w sprayu.
W preparatach, oprócz komórek macierzystych, obecne są również inne substancje mające pobudzać procesy regeneracyjne tkanek.
Za komórkami macierzystymi podawane są także:
- kolagen,
- elastyna,
- kwas hialuronowy.
Dzięki temu możliwe jest uzyskanie zdrowszej i bardziej elastycznej skóry po zranieniach, co wpływa na jakość procesu gojenia się ran i blizn. Warto również zauważyć, że komórki macierzyste same mają zdolność do namnażania się oraz wydzielania czynników wzrostu, co dodatkowo wspiera procesy regeneracyjne.
W Polsce Centrum Leczenia Oparzeń w Siemianowicach Śląskich jest jednym z ośrodków wykorzystujących komórki macierzyste w leczeniu ran i oparzeń, osiągając znakomite wyniki.
Sposoby podania i produkty pochodne
W praktyce komórki mogą być podawane miejscowo do łożyska rany, wstrzykiwane w jej otoczenie, osadzane w opatrunkach i rusztowaniach biomateriałowych lub stosowane w postaci frakcji komórkowych z tkanki tłuszczowej. Badane są również terapie oparte na produktach pochodnych (np. pęcherzykach zewnątrzkomórkowych/egzosomach), które dostarczają ten sam „sekretom”, ale bez żywych komórek.
Coraz więcej badań koncentruje się na roli komórek macierzystych w kontekście regeneracji funkcjonalnej, a nie tylko kosmetycznej. Skoncentrowano się na ocenie długoterminowych efektów i stabilności wyników terapii, aby lepiej zrozumieć ich rzeczywisty wpływ na poprawę jakości życia pacjentów z przewlekłymi ranami lub oparzeniami.
Dostępność, koszty i formalności

W wielu wskazaniach leczenie komórkami macierzystymi w ranach nadal ma charakter ograniczony do wyspecjalizowanych ośrodków i/lub badań klinicznych. Procedury te zwykle nie są standardowo refundowane i mogą wiązać się z istotnymi kosztami (ustalanymi indywidualnie przez ośrodki), a czasem z koniecznością kilkuetapowego leczenia i kontroli.
Warto sprawdzić, czy dana procedura jest realizowana w ramach badania klinicznego lub w oparciu o obowiązujące przepisy dotyczące zaawansowanych terapii (ATMP), czy posiada zgodę odpowiednich organów i komisji bioetycznej oraz jakie są łączne koszty całej ścieżki terapii i opieki po zabiegu.
O co zapytać przed kwalifikacją:
- status prawny procedury w ośrodku,
- doświadczenie zespołu,
- źródło i sposób przygotowania komórek,
- ryzyko i alternatywy,
- plan wizyt kontrolnych,
- przewidywane koszty łączne.
Bezpieczeństwo leczenia
Jak w przypadku innych interwencji, istnieje ryzyko miejscowych powikłań (ból, krwiak, zakażenie), a w przypadku preparatów allogenicznych – potencjalnych reakcji immunologicznych. Długoterminowa skuteczność i bezpieczeństwo zależą od wskazania, typu komórek i sposobu podania; dlatego kwalifikacja do terapii powinna być prowadzona przez doświadczony zespół w ośrodku posiadającym odpowiednie zaplecze i procedury nadzoru.
Źródła:
- Eamon Francis, Laura Kearney and James Clover, "The effects of stem cells on burn wounds: a review" (www.ncbi.nlm.nih.gov), www.ncbi.nlm.nih.gov, 2019
- Najath Abdul Kareem, Ayesha Aijaz, Marc G Jeschke, "Stem Cell Therapy for Burns: Story so Far" (www.ncbi.nlm.nih.gov), www.ncbi.nlm.nih.gov, 2021
- Yuan Li, Wei-dong Xia, Leanne Van der Merwe, Wen-tong Dai & Cai Lin, "Efficacy of stem cell therapy for burn wounds: a systematic review and meta-analysis of preclinical studies" (stemcellres.biomedcentral.com), stemcellres.biomedcentral.com/, 2020
- Jasmine Z Cheng, Ali Farrokhi, Aziz Ghahary, Reza B Jalili, "Therapeutic Use of Stem Cells in Treatment of Burn Injuries" (academic.oup.com), academic.oup.com, 2018
- Agnieszka Surowiecka, Anna Chrapusta, Maria Klimeczek - Chrapusta i inni, "Mesenchymal Stem Cells in Burn Wound Management" (www.mdpi.com), https://www.mdpi.com, 2022
- Sana Ullah, Sumaiya Mansoor, Aaima Ayub, "An update on stem cells applications in burn wound healing" (www.sciencedirect.com), www.sciencedirect.com, 2021

-
4.0/5 (opinie 8)